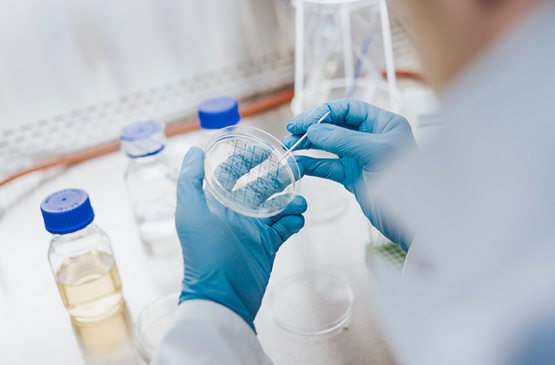
BIO Industry Analysis Report: The State of Innovation in Antibacterial Therapeutics

Antimicrobial Resistance (AMR) is a public health crisis.
Antimicrobial resistance (AMR) was associated with nearly 5 million deaths around the world in 2019. The number of fatalities is expected to grow to nearly 170 million deaths by 2050. AMR is one of the most serious public health threats today, but the market for antimicrobial development is broken.
Latest Insights on AMR
BIO Industry Analysis Report: The State of Innovation in Antibacterial Therapeutics
This report investigates recent investment into antibacterial innovation and the current clinical pipeline that will help bridge the gaps in the antibacterial armamentarium.
Working to Fight AMR
Working to Fight AMR aims to raise awareness of the threat of AMR and policy solutions that will help encourage the development of new antimicrobial medicines. Keep up with the latest AMR news, fact sheets, and more.

Biotechnology Innovation Organization
1201 New York Avenue NW, Suite 1300, Washington, DC, 20005 ・ 202-962-9200
© BIO 2025 All Rights Reserved






